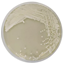

ProfiClave PC10B Agarpreparator, 1 x 230VAC, LNE (EU)
ProfiClave PC10B je plně automatický stolní sterilizátor pro přípravu hotových kultivačních médií, umožňující přípravu 9 l média v jedné dávce a její následné rozpipetování do Petriho misek, zkumavek či lahví.